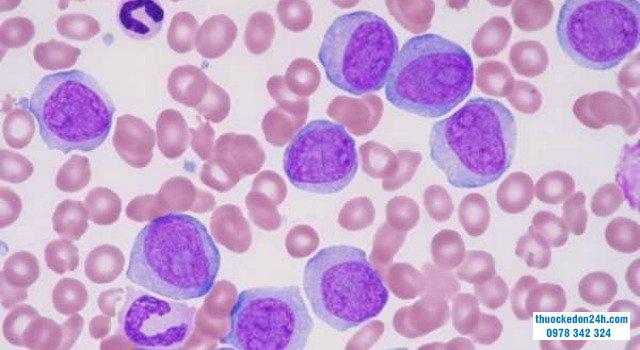
bạch cầu đơn nhân

Bài viết sau đây chúng ta cùng tìm hiểu về Viêm loét đại tràng là gì? Chuẩn đoán triệu chứng và điều trị.
Viêm loét đại tràng là một tình trạng viêm mãn tính không rõ nguyên nhân và có diễn tiến lâm sàng tái phát. Khoảng một nửa số bệnh nhân có một đợt bệnh nhẹ và dễ dàng quản lý bằng aminosalicylate, trong khi nửa còn lại cần ít nhất một đợt corticosteroid uống hoặc tiêm tĩnh mạch.
Trong số các loại thuốc sau, thuốc ức chế miễn dịch (bao gồm thiopurines và / hoặc tác nhân sinh học) được yêu cầu trong 75% trường hợp đối với chứng khúc xạ steroid, phụ thuộc steroid hoặc hoạt động bệnh mãn tính.
Ngay cả với các loại thuốc mạnh hơn hiện có, chỉ 30% đến 40% trong số những bệnh nhân đó đạt được kiểm soát bệnh thích hợp (tức là thuyên giảm lâm sàng) trong thời gian trung hạn như được đánh giá trong các thử nghiệm ngẫu nhiên có đối chứng (nghiên cứu ngẫu nhiên có đối chứng) và một tỷ lệ lớn trong số đó mất đi lợi ích điều trị ban đầu về lâu dài.
Ngoài ra, các thuốc ức chế miễn dịch làm tăng nguy cơ mắc các bệnh nhiễm trùng cơ hội/nghiêm trọng và ung thư, cũng như các kết quả bất lợi khác, chẳng hạn như làm trầm trọng thêm suy tim mãn tính và các biến chứng huyết khối tắc mạch, đặc biệt là ở những bệnh nhân cao tuổi khởi phát cao tuổi hoặc lâu năm, viêm loét đại tràng mãn tính và những người mắc các bệnh đồng mắc khác.
1. Điều chỉnh hoạt động và số lượng bạch cầu trung tính niêm mạc có thể là một phương pháp điều trị khả thi trong viêm loét đại tràng
Từ quan điểm gây bệnh, bạch cầu trung tính dường như đóng một vai trò quan trọng trong tổn thương mô. Cũng như trong các tình trạng viêm mãn tính khác, rối loạn điều hòa apoptosis của bạch cầu trung tính đã được quan sát thấy ở viêm loét đại tràng. Thâm nhiễm bạch cầu trung tính là một dấu hiệu của viêm loét đại tràng như được nhấn mạnh bởi thực tế, nó là một thành phần quan trọng của việc phân loại mức độ nghiêm trọng của viêm loét đại tràng trong một số điểm mô học.
Hơn nữa, sự hiện diện của bạch cầu trung tính trong sinh thiết đại tràng niêm mạc có liên quan đến nguy cơ tái phát lâm sàng và thậm chí là loạn sản, khiến một số tác giả coi sự thuyên giảm mô học là mục tiêu điều trị cuối cùng trong viêm loét đại tràng. Do đó, điều chỉnh hoạt động và số lượng bạch cầu trung tính niêm mạc có thể là một phương pháp điều trị khả thi trong viêm loét đại tràng, mặc dù chưa có loại thuốc nhắm mục tiêu vào các tế bào này.
Di chuyển bạch cầu hạt giúp điều trị viêm loét đại tràng
2. Hiệu quả điều trị của phương pháp di chuyển bạch cầu hạt / bạch cầu đơn nhân (GMA)
Hiệu quả điều trị của phương pháp di chuyển bạch cầu hạt / bạch cầu đơn nhân (GMA) dựa trên việc loại bỏ các bạch cầu trung tính đã hoạt hóa khỏi dòng máu mà không làm tăng nguy cơ nhiễm trùng, do các tế bào chưa trưởng thành được di chuyển từ các bể tạo máu. Tại Nhật Bản, phương pháp di chuyển bạch cầu hạt / bạch cầu đơn nhân đã được Bảo hiểm Y tế Quốc gia chi trả cho việc điều trị viêm loét đại tràng hoạt động kể từ tháng 4 năm 2000 và nó được sử dụng rộng rãi trong thực hành lâm sàng, ngay cả khi là liệu pháp đầu tay cho viêm loét đại tràng hoạt động mức độ trung bình đến nặng trong đơn trị liệu.
Tuy nhiên, mặc dù phương pháp di chuyển bạch cầu hạt / bạch cầu đơn nhân được đánh dấu CE để điều trị viêm loét đại tràng, bệnh Crohn, bệnh vẩy nến mụn mủ và bệnh Behçet ở Liên minh Châu Âu nhưng nó hầu như không được sử dụng ở Châu Âu.
Các kỹ thuật apheresis khác tập trung vào việc loại bỏ tế bào lympho đã được nghiên cứu trong quá khứ nhưng chúng hiện không có sẵn trên thị trường. Do một số khác biệt về đặc điểm di truyền, dịch tễ học và lâm sàng giữa viêm loét đại tràng phương Tây và Châu Á đã được báo cáo và những điều này có thể dẫn đến sự khác biệt trong phản ứng với các liệu pháp, các tác giả mong muốn đưa ra một cái nhìn tổng quan về cơ chế hoạt động, dữ liệu lâm sàng gần đây và các khía cạnh thực tế của việc sử dụng GMA trong viêm loét đại tràng từ góc độ Châu Âu.
3. Cơ chế hoạt động chọn lọc của phương pháp di chuyển bạch cầu hạt / bạch cầu đơn nhân
Phương pháp di chuyển bạch cầu hạt / bạch cầu đơn nhân là một kỹ thuật điện di chuyển từ tĩnh mạch đến tĩnh mạch ngoài cơ thể. Thiết bị để thực hiện phương pháp di chuyển bạch cầu hạt / bạch cầu đơn nhân có sẵn (Adacolumn TM , JIMRO, Takasaki, Nhật Bản) là một cột có chứa 35.000 hạt cellulose diacetate (đường kính 2 mm) như chất mang phương pháp di chuyển bạch cầu hạt / bạch cầu đơn nhân được ngâm trong nước muối đẳng trương trong vỏ polycarbonate 335 mL.
Máu chảy vào cột và trở lại bệnh nhân theo đường ra của cột, thường qua hai ống thông tĩnh mạch ngoại vi. Nhiều nghiên cứu lâm sàng, in vitro và ex vivo đã được thực hiện để xác định cơ chế hoạt động của phương pháp di chuyển bạch cầu hạt / bạch cầu đơn nhân. Tác dụng chính là loại bỏ có chọn lọc các tế bào hạt, bạch cầu đơn nhân, cùng với một số lượng nhỏ hơn các tiểu cầu khỏi dòng máu, có thể thấy được bằng cách so sánh số lượng của chúng trong cột dòng vào và dòng ra.
Các hạt xenlulo hấp thụ các globulin miễn dịch (Ig) G và các đơn vị miễn dịch trong tuần hoàn và kích hoạt sự hoạt hóa các mảnh bổ thể C3a và C5a, cho phép loại bỏ các tế bào hạt và bạch cầu đơn nhân thông qua sự tương tác của IgG và các đơn phân miễn dịch với thụ thể Fc gamma và các vị trí gắn kết của bổ thể bạch cầu, thụ thể (không có trong tế bào lympho). Do đó, các chất mang phương pháp di chuyển bạch cầu hạt / bạch cầu đơn nhân hấp phụ một cách chọn lọc các bạch cầu từ máu ngoại vi, với các bạch cầu hạt thể hiện ái lực cao nhất đối với các hạt chất mang.
Mặc dù loại bỏ bạch cầu hạt, tổng số bạch cầu hạt lưu hành sau khi phương pháp di chuyển bạch cầu hạt / bạch cầu đơn nhân vẫn ổn định. Trên thực tế, các nghiên cứu đo tế bào dòng chảy trong các dòng cột dòng vào và dòng ra đã quan sát thấy sự giảm CD10 (+) (trưởng thành và hoạt hóa) và sự gia tăng các tế bào hạt CD10 (-) (chưa trưởng thành, chưa hoạt hóa), cho thấy sự gia tăng số lượng của các tế bào này lưu thông.
Tương tự, sự giảm đáng kể các tế bào đơn nhân CD14 (+) và CD16 (+) ngoại vi (kiểu hình tiền viêm) đã được quan sát thấy ở những bệnh nhân bị bệnh viêm ruột được điều trị bằng phương pháp di chuyển bạch cầu hạt / bạch cầu đơn nhân . Cuối cùng, sự gia tăng đáng kể mức độ lưu hành của kiểu hình CD4+CD25high + / FoxP3 (tế bào T điều hòa chức năng) sau một đợt điều trị phương pháp di chuyển bạch cầu hạt / bạch cầu đơn nhân cũng đã được báo cáo ở bệnh nhân viêm loét đại tràng.

Sơ đồ cơ bản của quy trình điện di chuyển bạch cầu hạt
Các cơ chế hoạt động chính của của phương pháp di chuyển bạch cầu hạt / bạch cầu đơn nhân:
Trong bộ lọc hấp thụ
Trong máu của bệnh nhân
(1) Hấp thụ IgG lưu hành và các đơn giản miễn dịch bởi các hạt xenlulo;
(1) Giảm bạch cầu trung tính hoạt hóa và bạch cầu đơn nhân chống viêm (CD14 + CD16 +);
(2) Hoạt hóa các đoạn bổ thể (C3a, C5a);
(2) Tế bào apoptotic tương tác với tế bào B điều hòa, tạo ra IL-10 và tế bào B điều hòa trưởng thành;
(3) Hấp thu bạch cầu hạt và bạch cầu đơn nhân qua các thụ thể Fc𝛾 (IgG và immune complexes) và các vị trí liên kết của các thụ thể bổ thể bạch cầu (không có trong tế bào lympho);
(3) Sự trở lại của các chất do tế bào hấp phụ giải phóng: IL-1ra và HGF.
(4) Tạo ra tế bào apoptotic.
Ghi chú: IgG: Immunoglobulin G; IL: Interleukin; HGF: Yếu tố tăng trưởng tế bào gan.Nồng độ Cytokine chống viêm tỷ lệ thuận với số lượng tế bào bám vào chất mang:
Ngoài những thay đổi này trong kiểu hình của bạch cầu ngoại vi, các nghiên cứu in vitro sử dụng máu toàn phần của người ủ với chất mang phương pháp di chuyển bạch cầu hạt / bạch cầu đơn nhân đã đo lượng đáng kể chất đối kháng thụ thể interleukin (IL) -1, yếu tố tăng trưởng tế bào gan và yếu tố hoại tử khối u hòa tan (TNF) thụ thể I và II giải phóng từ bạch cầu hạt và bạch cầu đơn nhân bám vào chất mang.
Điều thú vị là số lượng các cytokine chống viêm này tỷ lệ thuận với số lượng tế bào bám vào chất mang. Một số cytokine này có thể đến được hệ tuần hoàn của bệnh nhân, có tác dụng có lợi đối với quá trình viêm. Cuối cùng, sự tiếp xúc của bạch cầu trung tính với các hạt cellulose dẫn đến việc tạo ra các tế bào apoptotic và hơn 40% các tế bào apoptotic này tái nhập vào máu của bệnh nhân và có thể tương tác với các tế bào B, tạo ra IL-10 sản xuất các tế bào B điều hòa.
Thông tin cần tư vấn liên hệ 0978342324 hoặc truy cập thuockedon24h.com để được hỗ trợ.
